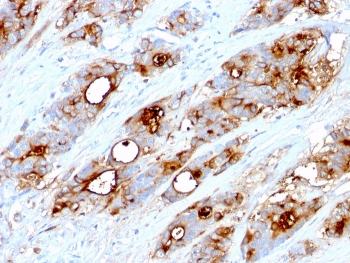
CEA Antibody / Carcinoembryonic Antigen
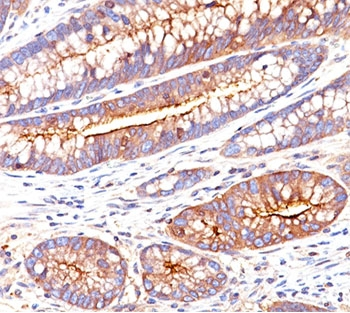
CEA Antibody / Carcinoembryonic Antigen

You have no items in your shopping cart.
CEA Antibody / Carcinoembryonic Antigen
Catalog Number: orb1151525
| Catalog Number | orb1151525 |
|---|---|
| Category | Antibodies |
| Description | Rabbit monoclonal antibody to CEA |
| Clonality | Recombinant |
| Species/Host | Rabbit |
| Isotype | Rabbit IgG |
| Conjugation | Unconjugated |
| Reactivity | Human |
| Immunogen | Recombinant full-length human CEA protein was used as the immunogen for the recombinant Carcinoembryonic Antigen antibody. |
| UniProt ID | P06731 |
| Tested applications | IHC-P |
| Dilution range | Immunohistochemistry (FFPE): 1-2ug/ml |
| Application notes | Optimal dilution of the recombinant Carcinoembryonic Antigen antibody should be determined by the researcher. |
| Antibody Type | Primary Antibody |
| Clone Number | C66/6470R |
| Formula | 0.2 mg/ml in 1X PBS with 0.1 mg/ml BSA (US sourced), 0.05% sodium azide |
| Storage | Maintain refrigerated at 2-8°C for up to 2 weeks. For long term storage store at -20°C in small aliquots to prevent freeze-thaw cycles. |
| Research Area | Apoptotic, Cancer, Epigenetics, Neuroscience, Sign Read more... |
| Note | For research use only |

IHC staining of FFPE human colon tissue with recombinant Carcinoembryonic Antigen antibody (clone C66/6470R). HIER: boil tissue sections in pH9 10mM Tris with 1mM EDTA for 20 min and allow to cool before testing.

Negative control: IHC staining of FFPE human brain tissue using recombinant Carcinoembryonic Antigen antibody (clone C66/6470R) at 2 ug/ml in PBS for 30 min RT. HIER: boil tissue sections in pH9 10mM Tris with 1mM EDTA for 20 min and allow to cool before testing.

SDS-PAGE analysis of purified, BSA-free recombinant Carcinoembryonic Antigen antibody (clone C66/6470R) as confirmation of integrity and purity.
CEA Antibody / Carcinoembryonic Antigen [orb248299]
IHC-P
Human
Mouse
Monoclonal
Unconjugated
20 μg, 100 μgCEA Antibody / Carcinoembryonic Antigen [orb248295]
IHC-P, WB
Human
Mouse
Monoclonal
Unconjugated
20 μg, 100 μgCEA Antibody / Carcinoembryonic Antigen [orb750192]
IHC-P, WB
Human
Mouse
Monoclonal
Unconjugated
20 μg, 100 μgCEA Antibody / Carcinoembryonic Antigen [orb248297]
IHC-P
Human
Mouse
Monoclonal
Unconjugated
20 μg, 100 μgCEA Antibody / Carcinoembryonic Antigen [orb749454]
IHC-P
Human
Mouse
Monoclonal
Unconjugated
20 μg, 100 μg
CEA Antibody / Carcinoembryonic Antigen (orb1151525)
Participating in our Biorbyt product reviews program enables you to support fellow scientists by sharing your firsthand experience with our products.
Login to Submit a Review